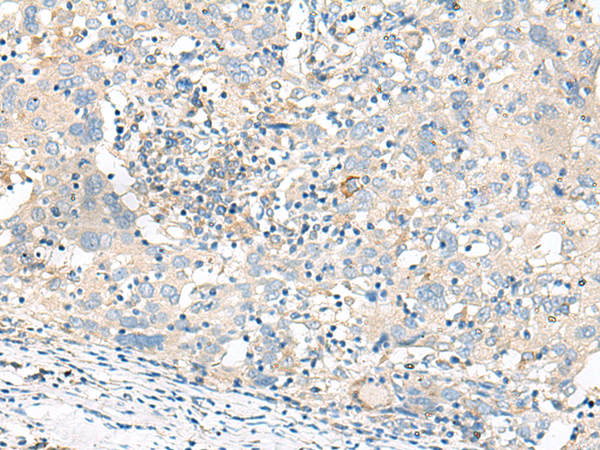

中文名稱: 兔抗GART多克隆抗體
儲 存: 冷凍(-20℃)
標(biāo) 記 物: Unconjugate
|
Background: |
The protein encoded by this gene is a trifunctional polypeptide. It has phosphoribosylglycinamide formyltransferase, phosphoribosylglycinamide synthetase, phosphoribosylaminoimidazole synthetase activity which is required for de novo purine biosynthesis. This enzyme is highly conserved in vertebrates. Alternative splicing of this gene results in two transcript variants encoding different isoforms. |
|
Applications: |
ELISA, IHC |
|
Name of antibody: |
GART |
|
Immunogen: |
Synthetic peptide of human GART |
|
Full name: |
phosphoribosylglycinamide formyltransferase, phosphoribosylglycinamide synthetase, phosphoribosylaminoimidazole synthetase |
|
Synonyms: |
AIRS; GARS; PAIS; PGFT; PRGS; GARTF |
|
SwissProt: |
P22102 |
|
ELISA Recommended dilution: |
5000-10000 |
|
IHC positive control: |
Human thyroid cancer and Human cervical cancer |
|
IHC Recommend dilution: |
30-150 |

購物車
幫助
021-54845833/15800441009
